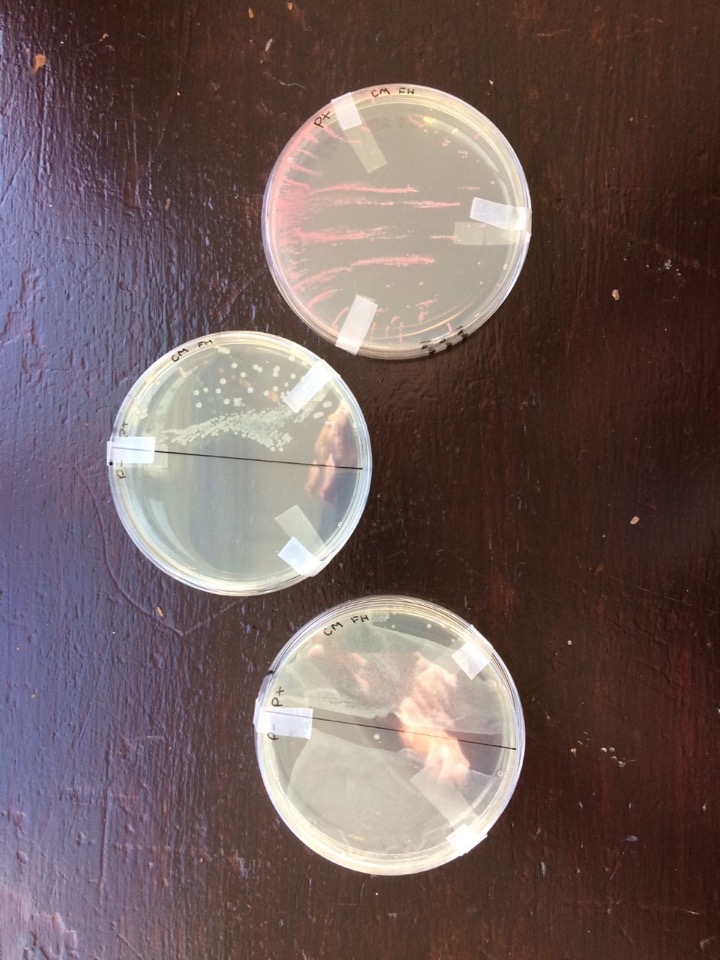
All Year 13 Biologists successfully transformed bacteria, well done <a href="/TSNphil/">Dr. Phil Smith</a> <a href="/ABEProgOffice/">Amgen Biotech Experience (ABE) Program Office</a> <a href="/STEM_UH/">Centre for STEM Education</a> #biotechexperience

Framlingham College Academic
@framacademic
The official Twitter page for all things 'Academic' at Framlingham College, a co-educational boarding and day school for boys and girls aged 2 - 18.
ID: 1050314829968433155
http://framcollege.co.uk 11-10-2018 09:19:04
688 Tweet
156 Takipçi
147 Takip Edilen

Year 13 students worked on the first stage of creating a recombinant plasmid for production of the red fluorescent protein (rfp). They used restriction digestion with two enzymes (BamHI and HindIII) to create linear DNA fragments from 2 known plasmids Amgen Biotech Experience (ABE) Program Office Centre for STEM Education



Have Year 13 been successful in making their recombinant plasmid? Well today they are a step closer to finding out by using agarose gel electrophoresis and then staining the DNA bands. The gels will be visualised tomorrow using a UV transilluminator Centre for STEM Education Amgen Biotech Experience (ABE) Program Office


Year 13 Biologists have had success in making their recombinant plasmid. Their gels were visualised Friday using a UV transilluminator #biotech #biotechexperience Dr. Phil Smith Amgen Biotech Experience (ABE) Program Office Centre for STEM Education


All Year 13 Biologists successfully transformed bacteria, well done Dr. Phil Smith Amgen Biotech Experience (ABE) Program Office Centre for STEM Education #biotechexperience

Today Year 13 Biologists explored one of the many uses of the polymerase chain reaction (PCR), learning about the enzyme DNA polymerase, sequence specific primers and thermal cycling. Dr. Phil Smith Centre for STEM Education Amgen Biotech Experience (ABE) Program Office #BiotechExperience




Super sleuthing today for Year 9s as they try and work out who murdered the Principal of Saxtead College, Mrs South. 😱 Scientific, maths and language skills needed. WHO? WHY? HOW? #CSI Framlingham College





